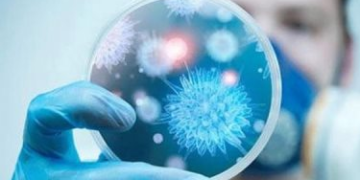

نفى مجلس الوزراء ما تردد من أنباء حول إعادة فتح قاعات الأفراح ودور المناسبات بدءاً من منتصف يوليو الجاري، مُؤكداً...
إقرأ المزيدتتوقع هيئة الأرصاد الجوية، أن يشهد اليوم الجمعة، ارتفاع طفيف فى درجات بحرارة الجو، حيث يسود طقس مائل للحرارة على...
إقرأ المزيدتعتبر المناديل الورقية، والأقنعة، والقفازات، أكثر المُخلفات أو النفايات الطبية التى قد تُسبب العدوى بفيروس كورونا، فى حال عدم الالتزام...
إقرأ المزيدأكدت وزارة الأوقاف، أن جميع المساجد ستؤذن لظهر اليوم الجمعة، بأذان النوازل، حيث لم تتخذ الوزارة بعد قرارا بإعادة فتح...
إقرأ المزيدقالت وزارة الصحة الكازاخستانية إن التحذيرات الصينية التي تحدثت عن حالات التهاب رئوي مجهولة ، أكثر خطورة من كورونا ،...
إقرأ المزيدمصر اليوم فى عيد ثورة 30 يونية ..الاحتفال السنوى السابع ثورة شعب مصر التى انتصرت فيها الامة المصرية بكل ابناؤها...
إقرأ المزيدكشفت أجهزة الأمن بالقليوبية، اليوم الجمعة، غموض مصرع طفلتين في شبرا الخيمة، بعدما زعمت الأم أن الوفاة نتيجة إصابتهما باختناق...
إقرأ المزيدأعلنت الدكتورة أمنية محمود خليفة، مدير مستشفى بنها التعليمي، تعافي وخروج 25 مصابا بفيروس كورونا، وتوجههم إلى منازلهم لاستكمال المرحلة...
إقرأ المزيدأمرت نيابة تمي الأمديد بمحافظة الدقهلية، اليوم، بحبس عامل 4 أيام على ذمة التحقيقات بتهمة الشروع في قتل زوجته، وإصابتها...
إقرأ المزيدجولة جديدة من مفاوضات سد النهضة، تخوضها مصر اليوم، في مجلس الأمن، وذلك بعدما أعلنت فرنسا عن نجاحها في عقد...
إقرأ المزيد